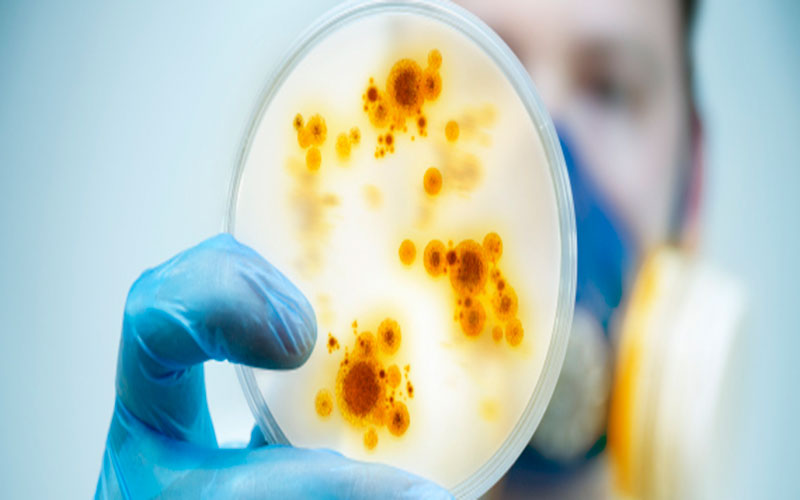

كشفت دراسة علمية جديدة أن الزجاجات القابلة لإعادة الاستخدام يمكن أن تحتوي على بكتيريا، تفوق 40 ألف مرة من متوسط عدد البكتريا الموجودة على مقعد المرحاض.
وتعد هذه النتائج صادمة بشأن زجاجات المياه القابلة لإعادة الاستخدام، والتي تعد بديلا عن الزجاجات البلاستيكية المصنعة للاستخدام مرة واحدة.
ووجد البحث المنشور على موقع "waterfilterguru.com" الأمريكي، أن الزجاجات القابلة لإعادة الاستخدام يمكن أن تحتوي على بكتيريا، تفوق 40 ألف مرة من متوسط عدد البكتريا الموجودة على مقعد المرحاض العادي، وفقا لصحيفة "نيويورك بوست" الأمريكية.
وللوصول إلى هذه النتيجة، قام الباحثون بمسح أجزاء مختلفة من زجاجة مياه 3 مرات لكل منها - بما في ذلك غطاء الفوهة وغطاء الماصة والغطاء العلوي المضغوط - ليكتشفوا نوعين من البكتيريا الموجودة، هي العصيات سالبة الغرام والبكتيريا.
ومن الممكن أن تسبب البكتيريا سالبة الغرام، التهابات تزداد مقاومة للمضادات الحيوية، بينما من الممكن أن تؤدي أنواع معينة من العصيات إلى مشاكل في الجهاز الهضمي، وفقا لوكالة سبوتينك.
كما اكتشف العلماء أن الزجاجات القابلة لإعادة الاستخدام، تحتوي على ضعف الجراثيم الموجودة على حوض المطبخ، ومن المكن أن تأوي أربعة أضعاف كمية البكتيريا الموجودة على فأرة الكمبيوتر، و14 مرة أكثر من وعاء الشرب الخاص بحيوان أليف.
واوضح عالم الأحياء الدقيقة الجزيئية في إمبريال كوليدج لندن، الدكتور أندرو إدواردز، في تصريحات لصحيفة "سيدني مورننغ هيرالد" الأمريكية، أن"فم الإنسان موطن لعدد كبير ومجموعة متنوعة من البكتيريا المختلفة، لذلك فإنه ليس من المستغرب أن تكون أوعية الشرب مغطاة بالميكروبات".
وعلى الرغم من أن الزجاجات القابلة لإعادة الاستخدام قد تكون بمثابة أرضا خصبة لأعداد كبيرة من البكتيريا، إلا أن عالم الأحياء الدقيقة في جامعة ريدنغ، الدكتور سايمون كلارك، يرى أنها "ليست بالضرورة خطيرة".
وقال: "لم أسمع قط عن مرض شخص ما بسبب زجاجة مياه، وبالمثل، من الواضح أن الصنابير ليست مشكلة، فمتى سمعت آخر مرة عن إصابة شخص ما بمرض من سكب كوب من الماء من الصنبور؟".
وويوصي خبراء الصحة بغسل الزجاجات القابلة لإعادة الاستخادم مرة واحدة على الأقل يوميا بالماء الساخن والصابون، وتعقيمها مرة واحدة على الأقل في الأسبوع.